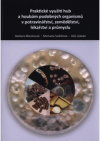
Praktické využití hub a houbám podobných organismů v potravinářství, zemědělství, lékařství a průmyslu

Barbora Mieslerová *1973
Časté štítky autorových děl
monografie obrazová publikace ekologie příroda pěstování houby koně rostlinolékařstvíPoslední navštívené (vypsat vše)
K otázce gnoseologických základů přestavby výchovně vzdělávacího systému a k jejímu společenskému významu
Zur Vertreibung und Aussiedlung der Sudetendeutschen aus dem Grenzgebiet Nordwestböhmens in die sowjetische Besatzungszone Deutschlands in den Jahren 1945 - 1946
Obecní řád saudní a řád konkursní Čech, Moravy, Slezska, Rakaus nad Enží i pod Enží, Štyrska, Korutan, Krajinska, Gorice, Gradišče, Terstu, Tyrol a Rakauských předzemítéž i předpis o stručném...